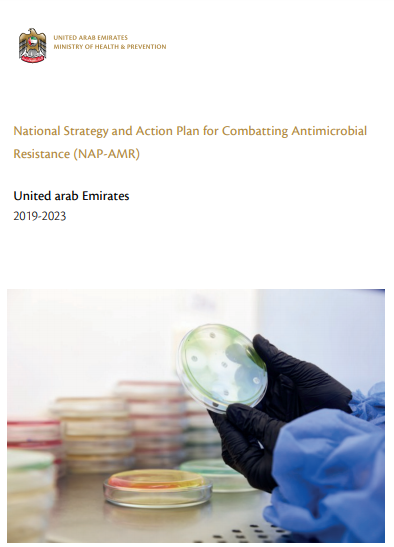

United Arab Emirates: National strategy and action plan for combatting antimicrobial resistance (NAP-AMR)
2019-2023
1 January 2019
| Publication
Other language versions
National Strategy and Action Plan for Combatting Antimicrobial Resistance (Arabic)
WHO Team
National Action Plans and Monitoring and Evaluation (NPM)
Number of pages
180
